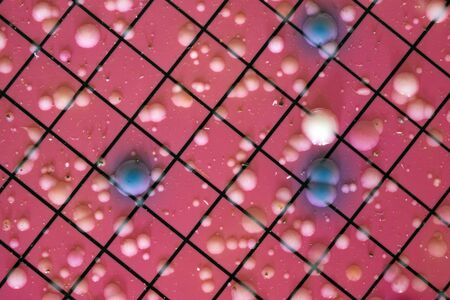
E. coli growing on DC media. Showing blue colonies for E. coli.の写真素材

写真素材 - E. coli growing on DC media. Showing blue colonies for E. coli.
作品情報
E. coli growing on DC media. Showing blue colonies for E. coli.
- ID:136376997
- 作品種別:写真
- 作者名:Geoffrey Whiteway
キーワード
- DC Media
- E coli
- Escherichia
- air
- bacteria
- bacterium
- biotechnology
- brilliance
- coli
- college
- colonies
- culture
- danger
- discovery
- disease
- dish
- education
- environment
- environmental
- experiment
- experimental
- food
- fungi
- germs
- health
- healthcare
- hygiene
- inspection
- lab
- laboratory
- medical
- medicine
- microbiology
- microorganism
- morphology
- pathogen
- petri
- plate
- quality
- research
- risk
- safety
- samples
- sanitation
- science
- selective
- sickness
- structure
- university
- water
類似作品
Conceptual imag...
Green bacteria ...
High-res image ...
Bacteria on a s...
Vibrant 3D rend...
A detailed digi...
High-definition...
Digital germs m...
Close-up of ger...
High-definition...
Microscopic bac...
Bacteria cells ...
cyan colored ba...
Close-up of ger...
Proliferating b...
Close-up of mic...
Close up view r...
3d rendered med...
Hands depicted ...
Visualizing Mic...
purple colored ...
Bacteria on a c...
Digital germs w...
Hidden Grocery ...
Unveil the hidd...
Close-up view o...
Microscopic Vie...
Explore a stunn...
Escherichia col...
Bacteria and vi...
Dangerous Water...
Surface contami...
Close-up of ger...
High-definition...
Microscopic Vie...
Bacteria, virus...
close up of 3d ...
Macro close up ...
High-definition...
3d Microscopic ...
Bacteria in mic...
Production line...
Probiotics bact...
Viruses in the ...
Diverse colorfu...
Escherichia Col...
Bacteria on a s...
Visualization o...